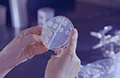

Эта статья предназначается всем, кто считает себя на работе незаменимым настолько, что живет многие годы с дискомфортом, а то и с настоящими болями, и не идет сдаваться к врачу.
Эта статья предназначается всем, кто считает себя на работе незаменимым настолько, что живет многие годы с дискомфортом, а то и с настоящими болями, и не идет сдаваться к врачу.
 Парапроктит – гнойное воспаление тканей, окружающих прямую кишку. Выделяют острый (впервые возникший) и хронический парапроктит (развивается как результат самопроизвольного или неправильного вскрытия (лечения) острого парапроктита).
Парапроктит – гнойное воспаление тканей, окружающих прямую кишку. Выделяют острый (впервые возникший) и хронический парапроктит (развивается как результат самопроизвольного или неправильного вскрытия (лечения) острого парапроктита).
 Амебиаз – это заболевание, при котором в толстой кишке обнаруживаются паразитические организмы – амебы. Если микроорганизмов в толстой кишке становится достаточно много, и они повреждают слизистую оболочку, инфекция проявлятся клинически и возникает амебная дизентерия. В случае тяжелого течения заболевания возможны такие осложнения, как обезвоживание, абсцесс печени, вовлечение головного мозга в инфекционный процесс. Обязательно проконсультируйтесь у врача, если у вас началась диарея с примесью крови или слизи в стуле.
Амебиаз – это заболевание, при котором в толстой кишке обнаруживаются паразитические организмы – амебы. Если микроорганизмов в толстой кишке становится достаточно много, и они повреждают слизистую оболочку, инфекция проявлятся клинически и возникает амебная дизентерия. В случае тяжелого течения заболевания возможны такие осложнения, как обезвоживание, абсцесс печени, вовлечение головного мозга в инфекционный процесс. Обязательно проконсультируйтесь у врача, если у вас началась диарея с примесью крови или слизи в стуле.
 Аппендицит – острое заболевание, в основе которого лежит воспаление аппендикса, червеобразного отростка слепой кишки. Такое состояние требует незамедлительной медицинской помощи.
Аппендицит – острое заболевание, в основе которого лежит воспаление аппендикса, червеобразного отростка слепой кишки. Такое состояние требует незамедлительной медицинской помощи.
 Аскаридоз – это паразитарное заболевание (гельминтоз), возбудителем которого является аскарида человеческая. Заражение человека происходит при проглатывании зрелых яиц аскарид. Фактором передачи инфекции служит почва. В терапии этого заболевания используют такие препараты как альбендазол, мебендазол, пирантел и пиперазин.
Аскаридоз – это паразитарное заболевание (гельминтоз), возбудителем которого является аскарида человеческая. Заражение человека происходит при проглатывании зрелых яиц аскарид. Фактором передачи инфекции служит почва. В терапии этого заболевания используют такие препараты как альбендазол, мебендазол, пирантел и пиперазин.
 Асцит, или брюшная водянка – это не самостоятельное заболевание, а состояние, возникающее вследствие различных серьезных заболеваний
Асцит, или брюшная водянка – это не самостоятельное заболевание, а состояние, возникающее вследствие различных серьезных заболеваний
 Болезнь Крона – это хроническое рецидивирующее заболевание неясной этиологии, характеризующееся гранулематозным воспалением с сегментарным поражением разных отделов пищеварительного тракта. Патологический процесс развивается преимущественно в кишечнике, хотя могут поражаться все отделы ЖКТ, включая пищевод и ротовую полость. Неспецифическое иммунное воспаление распространяется на всю толщу кишечной стенки и проявляется инфильтрацией лейкоцитами. В слизистой оболочке в зоне инфильтрации образуются глубокие язвы, развиваются абсцесс и свищи с последующим рубцеванием и сужением просвета кишки
Болезнь Крона – это хроническое рецидивирующее заболевание неясной этиологии, характеризующееся гранулематозным воспалением с сегментарным поражением разных отделов пищеварительного тракта. Патологический процесс развивается преимущественно в кишечнике, хотя могут поражаться все отделы ЖКТ, включая пищевод и ротовую полость. Неспецифическое иммунное воспаление распространяется на всю толщу кишечной стенки и проявляется инфильтрацией лейкоцитами. В слизистой оболочке в зоне инфильтрации образуются глубокие язвы, развиваются абсцесс и свищи с последующим рубцеванием и сужением просвета кишки
 Боли в животе варьируют от тупых или жгучих до острых и стреляющих и возникают при разных заболеваниях и состояниях. Если у вас возникла острая боль или повышенная чувствительность в правой нижней части живота, боли в животе при ходьбе, тошнота, рвота или потеря аппетита, повышенная температура тела, вам следует немедленно обратиться к врачу.
Боли в животе варьируют от тупых или жгучих до острых и стреляющих и возникают при разных заболеваниях и состояниях. Если у вас возникла острая боль или повышенная чувствительность в правой нижней части живота, боли в животе при ходьбе, тошнота, рвота или потеря аппетита, повышенная температура тела, вам следует немедленно обратиться к врачу.
 Вакцины против гепатита В представляют собой раствор, содержащий основной иммуногенный белок вируса гепатита В – HВs Ag. После введения вакцины в организме начинает формироваться специфический иммунитет. Полный курс вакцинации включает три введения и обеспечивает формирование стойкого иммунитета у 98% привитых.
Вакцины против гепатита В представляют собой раствор, содержащий основной иммуногенный белок вируса гепатита В – HВs Ag. После введения вакцины в организме начинает формироваться специфический иммунитет. Полный курс вакцинации включает три введения и обеспечивает формирование стойкого иммунитета у 98% привитых.
 Гастрит – это воспаление слизистой оболочки желудка. Различают острый и хронический гастрит. Бактерии Helicobacter pylori, колонизирующие слизистую оболочку желудка, выступают возбудителем наиболее частого из вариантов гастрита – гастрита с повышенной кислотностью желудочного сока.
Гастрит – это воспаление слизистой оболочки желудка. Различают острый и хронический гастрит. Бактерии Helicobacter pylori, колонизирующие слизистую оболочку желудка, выступают возбудителем наиболее частого из вариантов гастрита – гастрита с повышенной кислотностью желудочного сока.
 Изжога, отрыжка, неприятные ощущения за грудиной – эти симптомы часто говорят о развитии гастроэзофагеального рефлюкса, одного из наиболее распространенных заболеваний ЖКТ в наше время
Изжога, отрыжка, неприятные ощущения за грудиной – эти симптомы часто говорят о развитии гастроэзофагеального рефлюкса, одного из наиболее распространенных заболеваний ЖКТ в наше время
 Гастроэнтерит – это воспаление слизистой желудка и кишечника. Чаще всего его провоцируют инфекции: вирусные, бактериальные, протозойные, но есть и неинфекционные причины
Гастроэнтерит – это воспаление слизистой желудка и кишечника. Чаще всего его провоцируют инфекции: вирусные, бактериальные, протозойные, но есть и неинфекционные причины
Автор: Николаева Нина Борисовна, к.м.н.,
терапевт, диетолог, интегративный нутрициолог,
ninaboris2010@mail.ru
 Геморрой – это варикозное расширение геморроидальных вен прямой кишки, сопровождающееся такими симптомами как чувство дискомфорта и болезненности, кровотечение, выпадение геморроидальных узлов и др. Геморрой является одним из самых распространенных заболеваний всех цивилизованных стран.
Геморрой – это варикозное расширение геморроидальных вен прямой кишки, сопровождающееся такими симптомами как чувство дискомфорта и болезненности, кровотечение, выпадение геморроидальных узлов и др. Геморрой является одним из самых распространенных заболеваний всех цивилизованных стран.
 Гепатит – это воспаление печени, которое в некоторых случаях вызывается одним из вирусов. Симптомы включают усталость, головная боль, потеря аппетита, тошнота или рвота, повышение температуры до 38.8°С, желтуха (кожа, а также белки глаз становятся желтого оттенка), моча коричневого цвета, бесцветный кал, боль и сдавленность под ребрами справа.
Гепатит – это воспаление печени, которое в некоторых случаях вызывается одним из вирусов. Симптомы включают усталость, головная боль, потеря аппетита, тошнота или рвота, повышение температуры до 38.8°С, желтуха (кожа, а также белки глаз становятся желтого оттенка), моча коричневого цвета, бесцветный кал, боль и сдавленность под ребрами справа.
 Гепатомегалия – это увеличение печени сверх нормальных размеров, которое может сопровождаться диффузными изменениями. Нормы отличаются в зависимости от методов измерения и варьируются с учетом возраста, пола и роста человека
Гепатомегалия – это увеличение печени сверх нормальных размеров, которое может сопровождаться диффузными изменениями. Нормы отличаются в зависимости от методов измерения и варьируются с учетом возраста, пола и роста человека
 Диагностикой язвенной болезни занимается врач-гастроэнтеролог. На приеме врач соберет подробный анамнез. Он будет задавать вопросы о характере питания, ритме жизни, особенностях профессиональной деятельности и др. Далее врач проведет осмотр и пальпацию живота.
Диагностикой язвенной болезни занимается врач-гастроэнтеролог. На приеме врач соберет подробный анамнез. Он будет задавать вопросы о характере питания, ритме жизни, особенностях профессиональной деятельности и др. Далее врач проведет осмотр и пальпацию живота.
 Диарея (понос) – это частый жидкий стул, который может быть вызван различными причинами. Диарее часто сопутствуют спазмы в животе, рвота или высокая температура. У взрослых диарея редко бывает опасной. У детей разного возраста и у пожилых людей диарея может вызвать обезвоживание, что может привести к серьезным последствиям.
Диарея (понос) – это частый жидкий стул, который может быть вызван различными причинами. Диарее часто сопутствуют спазмы в животе, рвота или высокая температура. У взрослых диарея редко бывает опасной. У детей разного возраста и у пожилых людей диарея может вызвать обезвоживание, что может привести к серьезным последствиям.
 Лето, отпуск, море… Прекрасные закаты и романтические рассветы. Сердце заходится в приятом предвкушении, а в животе мечтательно порхают бабочки. И главное, чтобы кроме бабочек, ничего лишнего с нашими животами не случилось. Именно этому будет посвящена нынешняя статья, так как сегодня мы поговорим о «диарее путешественников».
Лето, отпуск, море… Прекрасные закаты и романтические рассветы. Сердце заходится в приятом предвкушении, а в животе мечтательно порхают бабочки. И главное, чтобы кроме бабочек, ничего лишнего с нашими животами не случилось. Именно этому будет посвящена нынешняя статья, так как сегодня мы поговорим о «диарее путешественников».
 Под диафрагмальной грыжей понимают перемещение органов из брюшной полости в грудную через естественное или патологическое отверстие в диафрагме. Диафрагма – это мышечная пластина, которая располагается между брюшной и грудной полостями тела.
Под диафрагмальной грыжей понимают перемещение органов из брюшной полости в грудную через естественное или патологическое отверстие в диафрагме. Диафрагма – это мышечная пластина, которая располагается между брюшной и грудной полостями тела.
 Дивертикулы – это грыжевидные выпячивания кишечной стенки, которые могут располагаться как в тонкой, так и в толстой кишке и обычно не сопровождаются никакими симптомнами. Однако в некоторых случаях может произойти воспаление дивертикула, которое и называется дивертикулитом.
Дивертикулы – это грыжевидные выпячивания кишечной стенки, которые могут располагаться как в тонкой, так и в толстой кишке и обычно не сопровождаются никакими симптомнами. Однако в некоторых случаях может произойти воспаление дивертикула, которое и называется дивертикулитом.
 Диетотерапия является ведущей в комплексном лечении хронического гастрита. Наиболее строгая диета назначается в период обострения. По мере улучшения самочувствия больного диета постепенно расширяется.
Диетотерапия является ведущей в комплексном лечении хронического гастрита. Наиболее строгая диета назначается в период обострения. По мере улучшения самочувствия больного диета постепенно расширяется.
 При дисбактериозе происходит изменение качественного и количественного состава микрофлоры кишечника – популяция полезных бифидо- и лактобактерий существенно уменьшается, а количество патогенных микроорганизмов растет.
При дисбактериозе происходит изменение качественного и количественного состава микрофлоры кишечника – популяция полезных бифидо- и лактобактерий существенно уменьшается, а количество патогенных микроорганизмов растет. Симптомы диспепсии относят к наиболее часто встречающимся проявлениям гастроэнтерологических заболеваний. Диспепсия сопровождается симптомами со стороны верхних отделов желудочно-кишечного тракта (ЖКТ)
Симптомы диспепсии относят к наиболее часто встречающимся проявлениям гастроэнтерологических заболеваний. Диспепсия сопровождается симптомами со стороны верхних отделов желудочно-кишечного тракта (ЖКТ)
.jpg) Печень принимает активное участие в обмене жиров. Жиры, поступающие с пищей расщепляются в кишечнике с помощью ферментов и всасываются в кровеносное русло. Оттуда они попадают в печень, где преобразуются в триглицериды, холестерин, фосфолипиды и другие необходимые для нашего организма вещества.
Печень принимает активное участие в обмене жиров. Жиры, поступающие с пищей расщепляются в кишечнике с помощью ферментов и всасываются в кровеносное русло. Оттуда они попадают в печень, где преобразуются в триглицериды, холестерин, фосфолипиды и другие необходимые для нашего организма вещества.
 Запор – это затрудненная, замедленная или недостаточно частая дефекация (опорожнение кишечника). В некоторых случаях запор может быть признаком более серьезного заболевания.
Запор – это затрудненная, замедленная или недостаточно частая дефекация (опорожнение кишечника). В некоторых случаях запор может быть признаком более серьезного заболевания.
 Изжога – это чувство жжения в области груди, которое может сопровождаться тошнотой, метеоризмом, отрыжкой, горьким или кислым привкусом во рту и в горле. Чаще всего изжога бывает после обильной пищи и в лежачем положении.
Изжога – это чувство жжения в области груди, которое может сопровождаться тошнотой, метеоризмом, отрыжкой, горьким или кислым привкусом во рту и в горле. Чаще всего изжога бывает после обильной пищи и в лежачем положении.
Соавтор, редактор и медицинский эксперт
Михаил Хецуриани
Изжога всегда является «звоночком», что в организме заболевшего что-то не так
Изжогой называется ощущение жжения за грудиной, которое распространяется от подложечной области вверх и даже может отдавать в шею
 При гепатите B основной способ, позволяющий снизить распространение инфекции и держать его под контролем, — иммунопрофилактика, осуществляемая при помощи вакцин и специфического иммуноглобулина.
При гепатите B основной способ, позволяющий снизить распространение инфекции и держать его под контролем, — иммунопрофилактика, осуществляемая при помощи вакцин и специфического иммуноглобулина.
Helicobacter pylori – это бактерия, которая паразитирует на слизистой оболочке желудка человека. Эти бактерии способны продуцировать и высвобождать большое количество ферментов и токсинов, которые способствуют повреждению клеток слизистой оболочки, что может приводить к развитию воспалительных и язвенных заболеваний желудка и двенадцатиперстной кишки.
Helicobacter pylori – это бактерия, которая паразитирует на слизистой оболочке желудка человека. Эти бактерии способны продуцировать и высвобождать большое количество ферментов и токсинов, которые способствуют повреждению клеток слизистой оболочки, что может приводить к развитию воспалительных и язвенных заболеваний желудка и двенадцатиперстной кишки.
Симптом изжоги знаком практически каждому человеку. Это состояние характеризуется ощущением жжения за грудиной, которое начинается в подложечной области и распространяется вверх
Пищевые факторы играют ключевую роль в механизме развития жжения в зоне пищевода
 Камни в желчном пузыре формируются из кристаллов холестерина или, реже – из желчных солей. Камни могут быть маленькими как песчинки или крупными, размером с грецкий орех. Холецистит или желчная колика, наблюдается, когда камень, находящийся в желчном пузыре, закупоривает желчный проток, по которому желчь поступает из желчного пузыря в тонкий кишечник.
Камни в желчном пузыре формируются из кристаллов холестерина или, реже – из желчных солей. Камни могут быть маленькими как песчинки или крупными, размером с грецкий орех. Холецистит или желчная колика, наблюдается, когда камень, находящийся в желчном пузыре, закупоривает желчный проток, по которому желчь поступает из желчного пузыря в тонкий кишечник.
 Лечение хронического гастрита является комплексным и включает рекомендации по диете и режиму питания, лекарственные препараты, физиотерапию и санаторно-курортное лечение. Выбор тактики лечения зависит от варианта хронического гастрита, секреторной функции желудка и этиологических факторов, которые могли привести к заболеванию.
Лечение хронического гастрита является комплексным и включает рекомендации по диете и режиму питания, лекарственные препараты, физиотерапию и санаторно-курортное лечение. Выбор тактики лечения зависит от варианта хронического гастрита, секреторной функции желудка и этиологических факторов, которые могли привести к заболеванию.
 Подходы к лечению язвенной болезнью значительно менялись на протяжении времени параллельно с тем, как менялись взгляды на ее происхождение. На сегодняшний день можно выделить несколько возможных механизмов ее формирования, хотя в целом патогенез язвенной болезни все еще остается недостаточно изученным.
Подходы к лечению язвенной болезнью значительно менялись на протяжении времени параллельно с тем, как менялись взгляды на ее происхождение. На сегодняшний день можно выделить несколько возможных механизмов ее формирования, хотя в целом патогенез язвенной болезни все еще остается недостаточно изученным.
 Метеоризм – это избыточное скопление газов в кишечнике, проявляющееся вздутием живота, ощущением дискомфорта в брюшной полости и отрыжкой. Газ выделяют бактерии при ферментации пищи, а воздух может заглатываться во время еды или разговора (обычно он выходит с отрыжкой). Метеоризм не является тяжелым или опасным заболеванием, однако часто становится причиной смущения и дискомфорта.
Метеоризм – это избыточное скопление газов в кишечнике, проявляющееся вздутием живота, ощущением дискомфорта в брюшной полости и отрыжкой. Газ выделяют бактерии при ферментации пищи, а воздух может заглатываться во время еды или разговора (обычно он выходит с отрыжкой). Метеоризм не является тяжелым или опасным заболеванием, однако часто становится причиной смущения и дискомфорта.
 Нарушения внешнесекреторной функции поджелудочной железы, сопровождающие заболевания органов пищеварения, на сегодняшний день – одна из самых актуальных тем в гастроэнтерологической и терапевтической практике.
Нарушения внешнесекреторной функции поджелудочной железы, сопровождающие заболевания органов пищеварения, на сегодняшний день – одна из самых актуальных тем в гастроэнтерологической и терапевтической практике.
 Неспецифический язвенный колит (НЯК) – это хроническое рецидивирующее заболевание кишечника иммунной природы, характеризующееся диффузным воспалением слизистой оболочки толстого отдела кишечника (прямой и ободочной кишки).
Неспецифический язвенный колит (НЯК) – это хроническое рецидивирующее заболевание кишечника иммунной природы, характеризующееся диффузным воспалением слизистой оболочки толстого отдела кишечника (прямой и ободочной кишки).Омез® 10 мг – лекарственный препарат из группы ингибиторов протонной помпы
 Острая кишечная непроходимость – это опасное для жизни патологическое состояние, которое характеризуется нарушением прохождения содержимого желудочно-кишечного тракта по направлению от желудка к заднему проходу и обычно бывает осложнением самых различных заболеваний. При отсутствии своевременного лечения прогноз при кишечной непроходимости крайне неблагоприятный.
Острая кишечная непроходимость – это опасное для жизни патологическое состояние, которое характеризуется нарушением прохождения содержимого желудочно-кишечного тракта по направлению от желудка к заднему проходу и обычно бывает осложнением самых различных заболеваний. При отсутствии своевременного лечения прогноз при кишечной непроходимости крайне неблагоприятный.
 Панкреатит – это воспаление поджелудочной железы. В обычных условиях пищеварительные ферменты находятся в клетках в инактивированном состоянии. Однако под действием различных факторов может произойти их активация, и они начнут переваривать паренхиму поджелудочной железы и собственные ткани организма с такой же легкостью, как и экзогенные пищевые продукты. Воспаление поджелудочной железы и выход пищеварительных ферментов в кровь обуславливает развитие тяжелейшей интоксикации.
Панкреатит – это воспаление поджелудочной железы. В обычных условиях пищеварительные ферменты находятся в клетках в инактивированном состоянии. Однако под действием различных факторов может произойти их активация, и они начнут переваривать паренхиму поджелудочной железы и собственные ткани организма с такой же легкостью, как и экзогенные пищевые продукты. Воспаление поджелудочной железы и выход пищеварительных ферментов в кровь обуславливает развитие тяжелейшей интоксикации. Печеночная недостаточность – симптомокомплекс, характеризующийся нарушением одной или многих функций печени вследствие острого или хронического повреждения ее ткани. Ежегодно в мире от фульминантной (молниеносной) печеночной недостаточности погибают 2 тыс. человек. Смертность от этого симптомокомплекса составляет 50-80%.
Печеночная недостаточность – симптомокомплекс, характеризующийся нарушением одной или многих функций печени вследствие острого или хронического повреждения ее ткани. Ежегодно в мире от фульминантной (молниеносной) печеночной недостаточности погибают 2 тыс. человек. Смертность от этого симптомокомплекса составляет 50-80%.
 Диета при заболеваниях печени и желчевыводящих путей должна способствовать восстановлению функционального состояния самой печени, нормализации процессов желчеобразования и желчевыделения, а также восстановлению нарушенного обмена веществ во всем организме.
Диета при заболеваниях печени и желчевыводящих путей должна способствовать восстановлению функционального состояния самой печени, нормализации процессов желчеобразования и желчевыделения, а также восстановлению нарушенного обмена веществ во всем организме.
 Правильное питание при язвенной болезни желудка является неотъемлемым компонентом терапии. Диету обычно характеризуют как механически, химически и термически щадящую. Частота приемов пищи увеличивается до 5 раз в сутки с перерывом в 3-4 часа.
Правильное питание при язвенной болезни желудка является неотъемлемым компонентом терапии. Диету обычно характеризуют как механически, химически и термически щадящую. Частота приемов пищи увеличивается до 5 раз в сутки с перерывом в 3-4 часа.
 Полипы прямой кишки - доброкачественные опухолевидные образования, растущие из стенки кишечника в его просвет. Любой полип следует рассматривать как предраковое заболевание. Однако длительно существующий полип может трансформироваться в злокачественную опухоль – колоректальный рак. Носителями этих опухолей могут быть как дети, так и взрослые.
Полипы прямой кишки - доброкачественные опухолевидные образования, растущие из стенки кишечника в его просвет. Любой полип следует рассматривать как предраковое заболевание. Однако длительно существующий полип может трансформироваться в злокачественную опухоль – колоректальный рак. Носителями этих опухолей могут быть как дети, так и взрослые.
Автор: Николаева Нина Борисовна, к.м.н.,
терапевт, диетолог, интегративный нутрициолог,
ninaboris2010@mail.ru
 Постхолецистэктомический синдром – это различные болезненные проявления, которые наблюдаются после удаления желчного пузыря. Постхолецистэктомический синдром не является самостоятельным заболеванием. ОН может возникать практически сразу после операции или отсрочено – через несколько месяцев или лет. Считается, что основной причиной постхолецистэктомического синдрома является нарушение циркуляции желчи. Однако возможны и другие причины.
Постхолецистэктомический синдром – это различные болезненные проявления, которые наблюдаются после удаления желчного пузыря. Постхолецистэктомический синдром не является самостоятельным заболеванием. ОН может возникать практически сразу после операции или отсрочено – через несколько месяцев или лет. Считается, что основной причиной постхолецистэктомического синдрома является нарушение циркуляции желчи. Однако возможны и другие причины.
 Проктит – воспаление слизистой оболочки прямой кишки. Развитию проктита могут способствовать переохлаждение, заболевания прямой кишки и соседних органов – геморрой, анальная трещина, парапроктит, абсцесс дугласова пространства, простатит, цистит, вульвовагинит и др. При отсутствии лечения может возникнуть такое осложнение, как сужение прямой кишки.
Проктит – воспаление слизистой оболочки прямой кишки. Развитию проктита могут способствовать переохлаждение, заболевания прямой кишки и соседних органов – геморрой, анальная трещина, парапроктит, абсцесс дугласова пространства, простатит, цистит, вульвовагинит и др. При отсутствии лечения может возникнуть такое осложнение, как сужение прямой кишки.
Изжога – это чувство жжения за грудиной, которое возникает в подложечной области и поднимается вверх
 Рвота чаще всего является результатом инфекции желудочно-кишечного тракта. В редких случаях она связана с бактериальной инфекцией, для устранения которой необходимо медикаментозное лечение. Однако в большинстве случаев она проходит сама в течение нескольких дней. Однако рвота может возникать и при других заболеваниях и состояниях, некоторые из которых требуют медицинского вмешательства.
Рвота чаще всего является результатом инфекции желудочно-кишечного тракта. В редких случаях она связана с бактериальной инфекцией, для устранения которой необходимо медикаментозное лечение. Однако в большинстве случаев она проходит сама в течение нескольких дней. Однако рвота может возникать и при других заболеваниях и состояниях, некоторые из которых требуют медицинского вмешательства.
 Рефлюкс-эзофагит представляет собой воспаление слизистой оболочки пищевода, обусловленное забросом желудочного содержимого в пищевод (желудочно-пищеводный рефлюкс). Одной из основных причин рефлюкс-эзофагита является грыжа пищеводного отверстия диафрагмы.
Рефлюкс-эзофагит представляет собой воспаление слизистой оболочки пищевода, обусловленное забросом желудочного содержимого в пищевод (желудочно-пищеводный рефлюкс). Одной из основных причин рефлюкс-эзофагита является грыжа пищеводного отверстия диафрагмы.
 Внутрижелудочная рН-метрия – это диагностическая процедура, в процессе которой производят измерение кислотности среды в желудке, пищеводе или двенадцатиперстной кишке. Этот метод получил широкое применение в гастроэнтерологии в связи с тем, что наиболее распространенные воспалительные заболевания желудочно-кишечного тракта имеют в своей основе изменения кислотности просвета органа.
Внутрижелудочная рН-метрия – это диагностическая процедура, в процессе которой производят измерение кислотности среды в желудке, пищеводе или двенадцатиперстной кишке. Этот метод получил широкое применение в гастроэнтерологии в связи с тем, что наиболее распространенные воспалительные заболевания желудочно-кишечного тракта имеют в своей основе изменения кислотности просвета органа.
 Синдром Жильбера – генетически обусловленная патология, при которой в определенные периоды повышен уровень билирубина, который в норме должен утилизироваться печенью
Синдром Жильбера – генетически обусловленная патология, при которой в определенные периоды повышен уровень билирубина, который в норме должен утилизироваться печенью
 Синдром нарушенного всасывания в кишечнике представляет собой широкий круг состояний, при которых нарушено усвоение различных питательных веществ.
Синдром нарушенного всасывания в кишечнике представляет собой широкий круг состояний, при которых нарушено усвоение различных питательных веществ.
 Синдром раздраженной толстой кишки обычно проявляется вздутием живота и спазмами и нарушениями работы кишечника. Симптомы СРКТ различаются у разных людей. Например, у одного – это запор (трудное и редкое опорожнение кишечника), у другого – диарея, а у третьего могут быть и те и другие симптомы одновременно. СРКТ не является тяжелым заболеванием.
Синдром раздраженной толстой кишки обычно проявляется вздутием живота и спазмами и нарушениями работы кишечника. Симптомы СРКТ различаются у разных людей. Например, у одного – это запор (трудное и редкое опорожнение кишечника), у другого – диарея, а у третьего могут быть и те и другие симптомы одновременно. СРКТ не является тяжелым заболеванием.
 Причины дисбактериоза кишечника – нерациональное питание, нерациональная антибиотикотерапия, хронические заболевания ЖКТ, острые инфекционные заболевания ЖКТ, гнойно-инфекционные заболевания, иммуннодефицитные состояния, стрессы.
Причины дисбактериоза кишечника – нерациональное питание, нерациональная антибиотикотерапия, хронические заболевания ЖКТ, острые инфекционные заболевания ЖКТ, гнойно-инфекционные заболевания, иммуннодефицитные состояния, стрессы.
 Ультразвуковое исследование (УЗИ) является в настоящее время одним из наиболее распространенных методов диагностики заболеваний брюшной полости. Несомненными достоинствами метода является скорость и простота выполнения и практически полная его безопасность.
Ультразвуковое исследование (УЗИ) является в настоящее время одним из наиболее распространенных методов диагностики заболеваний брюшной полости. Несомненными достоинствами метода является скорость и простота выполнения и практически полная его безопасность.
 Гастроскопия (ФГДС) является одной из разновидностей эндоскопического исследования, при которой врач осматривает с помощью специального прибора (гастроскопа) верхние отделы желудочно-кишечного тракта (пищевод, полости желудка и двенадцатиперстной кишки). ФГДС проводит в врач-эндоскопист.
Гастроскопия (ФГДС) является одной из разновидностей эндоскопического исследования, при которой врач осматривает с помощью специального прибора (гастроскопа) верхние отделы желудочно-кишечного тракта (пищевод, полости желудка и двенадцатиперстной кишки). ФГДС проводит в врач-эндоскопист.
 Целиакия – это хроническое аутоиммунное заболевание, сопровождающееся поражением тонкого кишечника при употреблении глютена
Целиакия – это хроническое аутоиммунное заболевание, сопровождающееся поражением тонкого кишечника при употреблении глютена
 Цирроз печени – прогрессирующее заболевание печени, характеризующееся перестройкой нормальной структуры печени, вследствие чего нарушаются функции печени, и развитием в последующем печёночной недостаточности и портальной гипертензии. В экономически развитых странах цирроз входит в число шести основных причин смерти пациентов от 35 до 60 лет.
Цирроз печени – прогрессирующее заболевание печени, характеризующееся перестройкой нормальной структуры печени, вследствие чего нарушаются функции печени, и развитием в последующем печёночной недостаточности и портальной гипертензии. В экономически развитых странах цирроз входит в число шести основных причин смерти пациентов от 35 до 60 лет.
Гастроэнтерологи уверяют, что самой распространенной причиной появления изжоги являются язвенная болезнь желудка, язва 12-перстной кишки, хронический гастрит
 Гастрит – распространенное заболевание, связанное с воспалением слизистой оболочки желудка. При эрозивном, или геморрагическом, гастрите слизистая не просто воспаляется, а начинает стираться, образуются кровотечения (эрозии). Эрозивный гастрит развивается медленно, на первых порах человек обычно игнорирует его симптомы. Поэтому заболевание поражает обширную часть слизистой желудка.
Гастрит – распространенное заболевание, связанное с воспалением слизистой оболочки желудка. При эрозивном, или геморрагическом, гастрите слизистая не просто воспаляется, а начинает стираться, образуются кровотечения (эрозии). Эрозивный гастрит развивается медленно, на первых порах человек обычно игнорирует его симптомы. Поэтому заболевание поражает обширную часть слизистой желудка.
 Эхинококкоз – заболевание человека и животных, вызываемое паразитированием личинок ленточного червя эхинококка. Заболевание может годами протекать бессимптомно. Клинические проявления возникают при увеличении кисты паразита в размерах и сдавлении окружающих органов. Лечение, в основном, хирургическое.
Эхинококкоз – заболевание человека и животных, вызываемое паразитированием личинок ленточного червя эхинококка. Заболевание может годами протекать бессимптомно. Клинические проявления возникают при увеличении кисты паразита в размерах и сдавлении окружающих органов. Лечение, в основном, хирургическое.
 Язвенная болезнь – это хроническое заболевание, в основе которого лежит рецидивирующая язва желудка или двенадцатиперстной кишки. Как правило, язва возникает на фоне гастрита (воспаление слизистой оболочки желудка) или дуоденита (воспаление слизистой оболочки двенадцатиперстной кишки), ассоциированного с инфекцией Helicobacter pylori. Язвенная болезнь встречается у людей любого возраста, но чаще в возрасте 30-40 лет, мужчины болеют в 6-7 раз чаще женщин.
Язвенная болезнь – это хроническое заболевание, в основе которого лежит рецидивирующая язва желудка или двенадцатиперстной кишки. Как правило, язва возникает на фоне гастрита (воспаление слизистой оболочки желудка) или дуоденита (воспаление слизистой оболочки двенадцатиперстной кишки), ассоциированного с инфекцией Helicobacter pylori. Язвенная болезнь встречается у людей любого возраста, но чаще в возрасте 30-40 лет, мужчины болеют в 6-7 раз чаще женщин.







